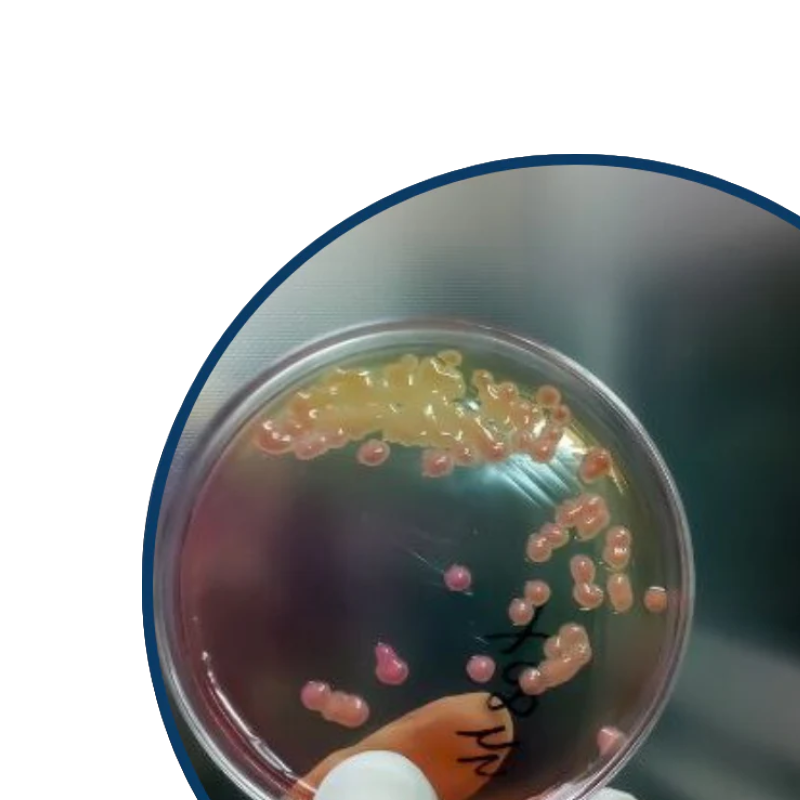

Honestly, I felt like such a bad mum giving my kids straight tap water for years. When I saw how black and slimy the filter was after just 3 weeks. It's truly shocking to see what was invisible in our 'clean' Sydney tap water. Thank God I found PuraHome before it was too late.
















What if the water your family drinks every day is quietly exposing them to over 100 invisible toxins?
The PuraHome™ Tap Water Filter uses 5-stage Advanced NanoFiltration — powered by natural coconut-activated carbon — to reduce over 100+ contaminants including PFAS, chlorine, lead, microplastics, pesticides, and more.
- Installs in under a minute — no plumber or tools required
- Easy side lever to switch between filtered and unfiltered water
- Each filter lasts up to 3 months with simple maintenance
Clean, safe water — without the fear of what’s hiding in your tap.
No plumber needed. No complicated setup. Just twist it on.
- Compatible with most standard taps (adapters included)
- Installs in less than 60 seconds
- Side lever lets you control when to filter
We’ve made it foolproof — because protecting your home should be that easy.
You can visit our install page for a video walkthrough on our website!
To keep your filter performing at its best, a quick clean is all it takes.
- Each filter lasts up to 3 months
- Use the included sandpaper to gently clean the surface every 2 weeks, or whenever buildup is visible
- Cleaning takes less than a minute and helps maintain strong flow and maximum filtration
You’ll see the difference — and that peace of mind is worth maintaining
Shipping
- Free shipping on all orders — no minimum spend
- All deliveries are fully trackable via Australia Post
Returns & Guarantee
- 30-night risk-free trial — not satisfied? Return it for a full refund
- Free returns — we cover the cost, no questions asked
- If anything breaks, leaks, or doesn’t fit — we’ll replace it or send out free parts
We're here to make it right, every step of the way.
Subscribe & Get the Filter Free — Just Cover Cartridges
Today: $99.99
Then: $79.99 every 4 or 6 months (for 6 months worth of filters = $13 per month for clean, fresh water)
What you get today
- Filter Base Unit — FREE (RRP ~$110)
- Cartridges for 6 months — INCLUDED
- 5× Universal Adapters — FREE (fits 90%+ taps; RRP ~$15)
- Free Shipping + Free Shipping Insurance
- Install Guide + Lifetime Support
- 30-Day Risk-Free Trial (we cover return shipping)
- Weekly “Win Your Order Back” Draw (T&Cs apply)
- Locked-In Protection — never run out, never worry about stock shortages.
- Cancel Anytime — no contracts, full control at your fingertips.
- Priority Family Safety — your home is always first in line for fresh filters.
Member Pricing on Refills
- List: ~$49.99/3 months → Subscribers: $39.99/3 months (~$20 off)
- Cadence: choose every 4 or 6 months depending on water usage for 2 filter refills; pause/skip anytime.
Or One-Off
- $109.99 (was $210) — filter + 2× cartridges, no member perks
- Save $100
Refills ship every 4 or 6 months automatically. You’ll get a reminder before each shipment, and you can skip, pause, or cancel anytime with one click.
PuraHome™ Tap Water Filter
As low as $27.49/month with
What You Can’t See… Might Be Hurting Your Family.
PuraHome doesn't just remove contaminants — it reveals them.
Transform your tap into a safer, healthier water source powered by PuraHome's Nanofiltration Filter.
Instantly Reveals & Removes 150+ Hidden Threats
Cleaner Water, Safer Home — In Just One Click
Installs in 60 Seconds — No Tools, No Plumber, No Excuses
- What’s included inside
- Extra Bonuses

PuraHome Tap Water FIlter

2 FREE Nanofiltation Filters

5 FREE Faucet Adapters

Effortless Refill Every 4 Months
FREE Shipping
FREE Shipping Insurance
FREE Returns
FREE Weekly Giveaway Entry
30-Night Risk Free Trial
Priority Customer Support
This product has limited availability.
78% already subscribed
Just pay for your cartridges
-
FREE Filter ($109.99 FREE)
-
6 months of Cartridges ($99.99 )
-
5 universal Adapters (universal fit for 90%+ taps)
-
FREE Entry to Win Your Order Back (Weekly Prize Draw)
-
FREE Shipping
-
FREE Shipping Insurance
-
FREE Step-by-Step Install Guide + Lifetime Support
-
30-Day Risk-Free Trial (love it or return it FREE)
-
Effortless Auto-Refill Every 6 months
-
20% off refill filters after 1st purchase (Only $13.33/month)
-
($99.99 first purchase | $79.98 every 6 months)
Our 4-month option is ideal for large families (4+) or homes with harder water (change every 2 months)
2 Filter cartridges delivered every:
Estimate delivery between
30 Day-Risk free-money back guanrantee
Adjust order intervals, skip orders, or pause. Cancel anytime.
Auto-Renewal Terms Discount codes not applicable to subscriptions unless otherwise specified.
Proof in Every Home
What if the water your family drinks every day is quietly exposing them to over 100 invisible toxins?
The PuraHome™ Tap Water Filter uses 5-stage Advanced NanoFiltration — powered by natural coconut-activated carbon — to reduce over 100+ contaminants including PFAS, chlorine, lead, microplastics, pesticides, and more.
- Installs in under a minute — no plumber or tools required
- Easy side lever to switch between filtered and unfiltered water
- Each filter lasts up to 3 months with simple maintenance
Clean, safe water — without the fear of what’s hiding in your tap.
No plumber needed. No complicated setup. Just twist it on.
- Compatible with most standard taps (adapters included)
- Installs in less than 60 seconds
- Side lever lets you control when to filter
We’ve made it foolproof — because protecting your home should be that easy.
You can visit our install page for a video walkthrough on our website!
To keep your filter performing at its best, a quick clean is all it takes.
- Each filter lasts up to 3 months
- Use the included sandpaper to gently clean the surface every 2 weeks, or whenever buildup is visible
- Cleaning takes less than a minute and helps maintain strong flow and maximum filtration
You’ll see the difference — and that peace of mind is worth maintaining
Shipping
- Free shipping on all orders — no minimum spend
- All deliveries are fully trackable via Australia Post
Returns & Guarantee
- 30-night risk-free trial — not satisfied? Return it for a full refund
- Free returns — we cover the cost, no questions asked
- If anything breaks, leaks, or doesn’t fit — we’ll replace it or send out free parts
We're here to make it right, every step of the way.
Subscribe & Get the Filter Free — Just Cover Cartridges
Today: $99.99
Then: $79.99 every 4 or 6 months (for 6 months worth of filters = $13 per month for clean, fresh water)
What you get today
- Filter Base Unit — FREE (RRP ~$110)
- Cartridges for 6 months — INCLUDED
- 5× Universal Adapters — FREE (fits 90%+ taps; RRP ~$15)
- Free Shipping + Free Shipping Insurance
- Install Guide + Lifetime Support
- 30-Day Risk-Free Trial (we cover return shipping)
- Weekly “Win Your Order Back” Draw (T&Cs apply)
- Locked-In Protection — never run out, never worry about stock shortages.
- Cancel Anytime — no contracts, full control at your fingertips.
- Priority Family Safety — your home is always first in line for fresh filters.
Member Pricing on Refills
- List: ~$49.99/3 months → Subscribers: $39.99/3 months (~$20 off)
- Cadence: choose every 4 or 6 months depending on water usage for 2 filter refills; pause/skip anytime.
Or One-Off
- $109.99 (was $210) — filter + 2× cartridges, no member perks
- Save $100
Refills ship every 4 or 6 months automatically. You’ll get a reminder before each shipment, and you can skip, pause, or cancel anytime with one click.

What Your Eyes Miss,
PuraHome Filter Catches.


Day 1
Day 10
How does tap water affect my family?

Lead
Neurotoxin
Common

Chlorine
& Cancer-Causing
Byproducts (THMs)
Common

PFAS
PFOA & PFOS
Common
Bacteria
& Parasites
Common

Heavy Metals
Arsenic, Mercury, etc
Common

Microplastics
Endocrine Disrupter
Common
Why Care?
Your home is where your family grows, sleeps and builds memories that last forever.
It’s where you’re meant to protect what matters most — your loved ones and their health.
But every single day, invisible toxins invade this 'safe' space through your tap water, silently putting your family’s health and future at risk.
You can’t see them.
But they’re there.
And they don’t stop at your glass.

Invisible chemicals like PFAS and chlorine by-products enter your home through tap water — found in 98% of Aussie homes, linked to kidney, liver, testicular, and endocrine cancers.
Source: World Health Organization (WHO)

Lead exposure increases the risk of ADHD, behavioural disorders, and cognitive impairments. Even tiny amounts of lead in tap water can permanently lower a child’s IQ and impair their brain development, especially during early growth years.
Source: Centers for Disease Control and Prevention

Microplastics disrupt hormones and weaken immunity, making your family more vulnerable to illness. If your child struggles with anxiety, focus, or mood swings, the water they’re drinking might be making it worse.
Source: National Institutes of Helath (NIH)

Chlorine and its by-products (THMs, HAAs) can trigger eczema, dry skin, and respiratory irritation— and are linked to cancer with long-term exposure.
Exposure to these can irritate the lungs, exacerbate asthma symptoms, and trigger respiratory inflammation, especially dangerous for young children and the elderly.
Source: National Institutes of Helath (NIH)

Bacterial biofilms in household pipes contaminate water, leading to digestive imbalances, infections, and chronic gut health problems.
Source: National Institutes of Helath (NIH)

PFAS ("Forever Chemicals") and microplastics in tap water interfere with hormone production, damaging reproductive health in both men and women — and are linked to reduced sperm counts, egg quality, and fertility issues over time.
Exposure to these toxins can disrupt puberty timing, menstrual cycles, and long-term reproductive function, silently increasing infertility risks for children, teenagers, and future generations.
Source: National Institutes of Helath (NIH)
Invisible chemicals like PFAS and chlorine by-products enter your home through tap water — found in 98% of Aussie homes, linked to kidney, liver, testicular, and endocrine cancers.
Source: World Health Organization (WHO)
Lead exposure increases the risk of ADHD, behavioural disorders, and cognitive impairments. Even tiny amounts of lead in tap water can permanently lower a child’s IQ and impair their brain development, especially during early growth years.
Source: Centers for Disease Control and Prevention
Microplastics disrupt hormones and weaken immunity, making your family more vulnerable to illness. If your child struggles with anxiety, focus, or mood swings, the water they’re drinking might be making it worse.
Source: National Institutes of Helath (NIH)
Chlorine and its by-products (THMs, HAAs) can trigger eczema, dry skin, and respiratory irritation— and are linked to cancer with long-term exposure.
Exposure to these can irritate the lungs, exacerbate asthma symptoms, and trigger respiratory inflammation, especially dangerous for young children and the elderly.
Source: National Institutes of Helath (NIH)
Bacterial biofilms in household pipes contaminate water, leading to digestive imbalances, infections, and chronic gut health problems.
Source: National Institutes of Helath (NIH)
PFAS ("Forever Chemicals") and microplastics in tap water interfere with hormone production, damaging reproductive health in both men and women — and are linked to reduced sperm counts, egg quality, and fertility issues over time.
Exposure to these toxins can disrupt puberty timing, menstrual cycles, and long-term reproductive function, silently increasing infertility risks for children, teenagers, and future generations.
Source: National Institutes of Helath (NIH)






Independanly Lab Tested
Australian tap water contains over 100 hidden contaminants — and most filters barely scratch the surface.

Before

After
See the impact in just 2 weeks
of families noticed better tasting water
felt more confident using tap water
saw visible change in their filter
reduced bottled water use at home
In certified lab tests¹
150+
Dangerous contaminants targetedIn certified lab tests¹
0.2
Micron Filtration26x
finer filtration than standard jugs¹ Testing performed by independent third-party accredited laboratories. Actual results may vary depending on local water quality and proper installation.

Clean Water. Clear Benefits

Immunity
Reduced Exposure to Immune-Disrupting Contaminants
Filters out microplastics, bacteria, and heavy metals — reducing your family’s exposure to substances known to weaken immune defences.

Brain Development
Supports Healthy Brain Development
Designed to reduce lead and PFAS, which are linked to developmental delays, attention difficulties, and cognitive impairments in children.

Cancer Risk
Minimises Contact with Cancer-Linked Contaminants
Targets and reduces exposure to PFAS, chlorine by-products, and heavy metals — substances that have been associated with long-term health risks.

Fertility
Reduces Exposure to Fertility-Impacting Chemicals
Helps lower your family’s exposure to PFAS and microplastics — contaminants associated with reproductive health risks and hormonal disruption.

Skin & Respiratory
Helps Minimise Skin & Respiratory Irritants
Filters chlorine and disinfection by-products (THMs, HAAs) that may contribute to skin dryness, irritation, and respiratory discomfort.

Proof
Visual Proof of Cleaner Water
Watch your filter change colour as it captures contaminants, giving you visible reassurance that your family’s water is being filtered effectively.

Digestive Health
Improves Water Quality for Digestive Health
Removes bacteria and biofilm residues that can compromise the quality of your tap water and impact digestive wellness.

Hydration
Healthier Hydration, Peace of Mind
Enjoy water that’s not only clean and refreshing, but also free from contaminants that may compromise your family’s long-term wellbeing.
PuraHome NanoFiltration Technology
PuraHome’s advanced 5-stage nanofiltration system captures contaminants at 0.2 micron level—removing what ordinary filters miss and giving your family the purest, safest water, visibly proven with every use.


Initial Filtration: Stainless Steel - stage 1
WHAT IT DOES
This layer is the first line of defence in the filtration process. It contains tiny holes that are small enough to trap large particles like dirt, rust, and sand as the water flows through. This helps to clean the water by removing these visible impurities right at the start, making it safer and clearer for the next filtration stages.

Fine Filtration: Diatom Natural Clay - stage 2
WHAT IT DOES
This layer uses a special type of natural material called diatomaceous earth. This material is made up of tiny fossilised remains of algae. When water passes through this layer, it acts like a fine filter, catching very small particles, bacteria, and some chemicals that the first layer might have missed.

Adsorption of impurities: Activated charcoal - stage 3
WHAT IT DOES
Activated charcoal layer uses a highly porous material that works like a sponge. When water passes through it, the charcoal attracts and holds onto impurities like chlorine, chemicals, and bad odors. This process not only makes the water taste and smell better but also removes harmful substances, making the water safer to drink.

Secondary Fine Filtration: PP cotton - stage 4
WHAT IT DOES
PP cotton (polypropylene) layer acts as an additional filter. Made from fine fibers, it captures smaller particles that the previous layers might have missed, such as tiny bits of dust and sediment. This step ensures that even finer impurities are removed, further purifying the water and making it cleaner for the next filtration stages.

Enhanced Filtration: Stainless Steel 2 - stage 5
WHAT IT DOES
Stainless Steel 2 provides an additional filtration step, capturing any remaining fine particles that may have passed through earlier stages. Its very fine pores ensure thorough purification, removing even the smallest impurities. This step is crucial for delivering water that is exceptionally clean and free of contaminants, enhancing both its safety and quality before it reaches the final filtration stage.
PuraHome: The New Gold Standard

PuraHome

Other Tap Filters

Filter Jugs

Reverse Osmosis
Efficient Filtration (0.2 Micron)
Retains Healthy Minerals
Visible Proof
Installs in Seconds, No Tools Required
Portable & Travel Friendly
Real-Time Filtration (No Waiting)
Affordable Price
Low Maintenance
Doesn't Waste Water
Real Customers. Real Protection.
A new standard in home water safety
PuraHome™ Nanofiltration is the ONLY tap filter designed to visibly capture 150+ hidden contaminants right from your faucet.
Protect Your Home5-Stage Filtration : Blocks 150+ contaminants
Visible Filter Change : See the dirt it traps
Preserves essential minerals : in your tap water while making it lighter and fresher.
No Tools Needed : Fits 95% of taps & Installs in seconds
Compact Design : Space-saving and durable
Long Filter Life : Lasts up to 3 months
Easy Replacement : Twist-and-lock system
Fast Water Flow : 2L per minute
Simple, no tools, 30 second install.
PuraHome™ fits the 95% of standard kitchen taps right out of the box.
If your tap is a different shape or size, no problem — we offer a range of adapter options so you can get the perfect fit.
Simply check your tap style at checkout and add the adapter you need to your order.
Frequently Asked Questions
How does the PuraHome™ Tap Water Filter clean my water?
It uses a 5-stage Advanced NanoFiltration system with coconut-activated carbon to reduce 100+ contaminants, including PFAS, chlorine, lead, microplastics and pesticides for safer, fresher-tasting water at the tap.
Will it fit my tap?
Yes, PuraHome includes adapters and is compatible with most standard taps! The unit twists on in under 60 seconds. If your tap is unusual, we have extra adapter options to get a snug fit. For additional adapters click here!
How long does a cartridge last, and how do I maintain it?
Each cartridge lasts up to 3 months. To keep flow strong, give the ceramic surface a light clean with the included sandpaper every couple of weeks or when buildup is visible; this helps maintain maximum filtration until replacement time.
Does the filter reduce water pressure?
The system is designed for everyday kitchen use and strong flow; routine surface cleaning (as above) helps sustain performance and pressure over the cartridge’s life.
Can I switch between filtered and unfiltered water?
Yes, the side lever lets you toggle instantly. Use filtered water for drinking/cooking and unfiltered for tasks like rinsing to extend cartridge life.
How small are the particles it captures?
The nanofiltration tech targets contaminants at 0.2-micron scale, far beyond basic mesh screens and standard carbon alone.
Can temperature changes crack the ceramic filter?
Yes, ceramic can fracture from heat. Run the tap water filter in cold or room-temperature water only. Avoid sustained hot water and sudden hot - cold switches while in filtered mode (use the lever to switch to unfiltered for hot water). If you ever notice a hairline crack or a sudden drop in flow/taste quality after a heat exposure, replace the cartridge to maintain safe, effective filtration.
Is it third-party tested?
Yes. Our filters are independently tested by accredited third-party labs against international drinking water standards (GB 5749–2022 and GB/T 5750 methods). Results show reductions in chlorine, heavy metals, turbidity, and more under lab conditions. Performance in your home may vary depending on local water quality and filter care.
Affordable, Planet – Friendly Protection
You could spend each year :
- $2,000+ on bottled water
- $1,500+ on Reverse Osmosis Systems
- $300+ on Filter Jugs
PuraHome does it better, for a fraction of the cost — $0.30 per day.
30 Day-Risk free-money back guarantee
